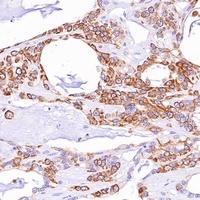
Goat Mouse/Rabbit IgG (H&L)-HRP Polymer (Ready to use) Antibody

You have no items in your shopping cart.
Goat Rabbit IgG Secondary Antibody HRP Conjugated
Description
Images & Validation
−
| Dilution Range | IHC/ICC: 1:500 - 1:5,000 ELISA: 1:5,000 - 1:50,000 Western blot: 1:5,000 - 1:50,000 |
|---|---|
| Reactivity | Rabbit |
| Application Notes |
Key Properties
−| Antibody Type | Secondary Antibody |
|---|---|
| Clonality | Polyclonal |
| Conjugation | HRP |
Storage & Handling
−| Storage | Store at -20°C/1 year |
|---|---|
| Expiration Date | 12 months from date of receipt. |
| Disclaimer | For research use only |
Similar Products
−Rabbit IgG (H&L) Secondary Antibody Peroxidase Conjugated Pre-adsorbed [orb347654]
DOT, ELISA, IHC, WB
Rabbit
Goat
Polyclonal
HRP
1 mgRabbit IgG (H&L) Antibody Peroxidase Conjugated Pre-Adsorbed [orb347676]
ELISA, IHC, WB
Rabbit
Goat
Polyclonal
HRP
2 mgGoat Anti-Mouse/Rabbit IgG (H&L)- Polymer (Ready to use) Antibody (HRP) [orb1878754]
ELISA, ICC, IHC, WB
Mouse, Rabbit
Goat
Polyclonal
HRP
10 ml, 100 mlGoat Anti-Mouse/Rabbit IgG (H&L)- Polymer Antibody (HRP) [orb1878757]
ELISA, ICC, IHC, WB
Mouse, Rabbit
Goat
Polyclonal
HRP
100 μl, 500 μl, 1 mlRabbit IgG (H&L) Secondary Antibody Peroxidase Conjugated [orb347673]
ELISA, IHC, WB
Rabbit
Goat
Polyclonal
HRP
2 mg

Quality Guarantee
Explore bioreagents carefree to elevate your research. All our products are rigorously tested for performance. If a product does not perform as described on its datasheet, our scientific support team will provide expert troubleshooting, a prompt replacement, or a refund. For full details, please see our Terms & Conditions and Buying Guide. Contact us at [email protected].
Documents Download
Request a Document
Protocol Information
Filter by Applications
Filter by Species
Althenayyan, Saleh et al. Alternatively Spliced Isoforms of MUC4 and ADAM12 as Biomarkers for Colorectal Cancer Metastasis J Pers Med, 13, 135 (2023)
Applications
Reactivity
Zahra Azarmehr 1 2 3, Fatemeh Poshtareh 4, Nafiseh Shafiei 5, Armaghan Shirinsokhan 6, Fereshteh Rahmati 7 The neuroprotective effect of N-acetylcysteine by regulating inflammation and expression of TNF-α and ERK gene expression in the rats exposed to different doses of cadmium Mol Biol Rep, (2025)
Applications
Reactivity
Khan, Aamir Ali et al. WBSCR22 and TRMT112 synergistically suppress cell proliferation, invasion and tumorigenesis in pancreatic cancer via transcriptional regulation of ISG15 Int J Oncol, 60, 24 (2022)
Applications
Reactivity
Goat Rabbit IgG Secondary Antibody HRP Conjugated (orb43514)
Participating in our Biorbyt product reviews program enables you to support fellow scientists by sharing your firsthand experience with our products.
Login to Submit a Review